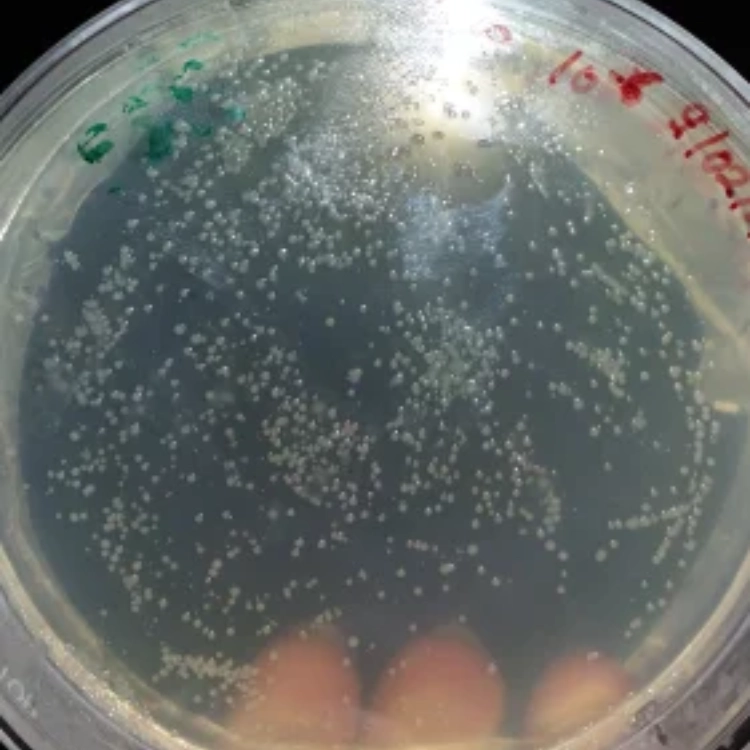
Azotobacter Biofertilizer-img2 Azotobacter Biofertilizer-img2

Bio Fertilizers
Eco-friendly bio fertilizers that enhance soil health, improve nutrient absorption, and boost crop yields naturally for long-term agricultural productivity.
- Azospirillum Biofertilizer is a highly efficient nitrogen-fixing microbial formulation designed to enhance root development, improve nutrient uptake, and boost crop productivity. It contains selected strains of Azospirillum bacteria that colonize the root zone and convert atmospheric nitrogen into plant-available forms, thereby reducing the need for chemical nitrogen fertilizers and supporting sustainable farming practices. When applied to soil, seeds, or seedlings, Azospirillum stimulates vigorous root growth through the production of growth-promoting substances such as indole acetic acid (IAA), gibberellins, and vitamins. This results in stronger root systems, improved plant establishment, and enhanced tolerance to environmental stresses such as drought, salinity, and poor soil conditions. Azospirillum Biofertilizer increases chlorophyll content, boosts photosynthetic efficiency, and promotes healthier vegetative growth, ultimately leading to higher yields. It also enhances soil microbial activity, improves soil structure, and contributes to long-term fertility. Suitable for cereals, millets, oilseeds, vegetables, sugarcane, cotton, and horticultural crops, this biofertilizer is a reliable companion for modern, eco-friendly crop cultivation. With consistent use, farmers benefit from reduced fertilizer costs, improved crop vigor, and better-quality produce—all while maintaining soil health and promoting environmentally responsible agriculture.
For Enquiry

Azotobacter Biofertilizer is a highly effective, free-living nitrogen-fixing microbial formulation designed to improve soil fertility and promote vigorous plant growth. It contains active strains of Azotobacter bacteria that naturally convert atmospheric nitrogen into a plant-available form, enriching the soil and reducing dependence on chemical fertilizers.
When applied to soil or seed, Azotobacter colonizes the rhizosphere and supplies a steady release of nitrogen throughout the crop cycle. This enhances root development, improves nutrient uptake, and supports stronger vegetative growth. Along with nitrogen fixation, the bacteria produce growth-promoting substances such as vitamins, amino acids, and phytohormones (IAA, GA), which boost seed germination, plant vigor, and overall productivity.
Azotobacter Biofertilizer also improves soil structure, increases microbial activity, and enhances organic matter decomposition—resulting in better aeration and moisture retention. It helps crops withstand environmental stress, improves resistance to diseases, and supports sustainable farming by restoring the natural microbial balance of the soil.
Suitable for a wide range of crops including cereals, pulses, vegetables, fruits, oilseeds, cotton, and plantation crops, Azotobacter Biofertilizer is an eco-friendly solution for improving yield, soil health, and long-term agricultural sustainability.
For Enquiry

PSB (Phosphorus Solubilizing Bacteria) is a powerful biofertilizer and eco-friendly microbial formulation containing beneficial bacterial strains such as Bacillus and Pseudomonas species capable of solubilizing locked or insoluble phosphates in soil and water.
By converting unavailable phosphorus into soluble forms, PSB enhances nutrient absorption, promotes healthy plankton growth in aquaculture ponds, and improves plant root development in agriculture.
Regular application enriches the microbial population, supports ecological balance, and boosts the overall productivity of the farming system.Key Benefits
Converts insoluble phosphates into plant- and plankton-available forms
Enhances natural plankton growth in aquaculture ponds
Improves nutrient uptake and root growth in crops
Boosts water fertility and pond productivity
Reduces dependency on chemical phosphorus fertilizers
Promotes healthy microbial balance in soil and water
Eco-friendly, safe, and residue-free
Applications
Aquaculture (fish & shrimp ponds)
Agriculture & horticulture
Pond preparation and water fertility enhancement
Soil nutrient enrichment and crop development
Organic and sustainable farming systems
For Enquiry

Vesicular Arbuscular Mycorrhiza (VAM) is a powerful biofertilizer containing beneficial mycorrhizal fungi that form symbiotic associations with plant roots, significantly enhancing nutrient absorption and overall plant performance. These fungi penetrate root tissues and extend a vast network of microscopic hyphae into the soil, acting as an extended root system that improves the uptake of essential nutrients—especially phosphorus, along with zinc, copper, and other micronutrients.
By increasing the effective root surface area, VAM enables plants to thrive even in nutrient-deficient, stress-prone soils. It enhances root development, improves water absorption, and boosts plant resilience against drought, salinity, soil-borne pathogens, and transplant shock. The mycorrhizal association also enhances soil structure by binding soil particles, improving aeration, moisture retention, and long-term soil health.
VAM promotes stronger vegetative growth, higher flowering and fruiting, improved yield quality, and overall better plant vigor. It is ideal for field crops, vegetables, fruits, ornamentals, plantation crops, nurseries, and horticulture systems. As a natural and eco-friendly biofertilizer, VAM reduces dependence on chemical phosphorus fertilizers and supports sustainable agricultural practices.
Whether used during seed treatment, nursery application, or field transplantation, Vesicular Arbuscular Mycorrhiza provides a long-lasting biological advantage that boosts productivity while improving soil ecology.
For Enquiry